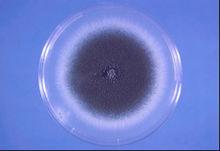
煙麴黴的菌落

基本信息
門:半知菌類 Fungi
科:叢梗孢科 Moniliaceae
屬:麴黴屬 Aspergillus
種:煙麴黴 Aspergillus fumigatus
分類地位:菌物界 > 無性型真菌門 > 半知菌綱 > 殼霉目 > 杯霉科 > 煙麴黴屬
保護級別:未列入
瀕危等級:無危
煙麴黴的菌落
煙麴黴的菌落可信度:3級可信度
野生馴化:野生
水生陸生:陸生
重慶特有種:否
重慶模式種:否
定名人: Fres.
棲息地類型: 不定
生境描述: 本種喜高溫,在45℃時生長很好。
用途類別: 有害
分 布: 分布於世界各地。
危害影響
本菌為致病菌,能引起人、畜和禽類的肺麴黴病及其他疾病。侵染棉鈴和蘋果等,引起果實腐爛,或寄藏於種子上。
危害: 棉花(棉鈴麴黴病)
識別特徵
 煙麴黴
煙麴黴分生孢子穗圓筒形,呈深淺不同的綠色;分生孢子梗光滑,帶綠色;頂囊燒瓶狀,僅上半部產生孢子;分生孢子球形,有刺,綠色。
生物現狀
保護及保存現狀:人工保存
主要用途和價值:引起食品腐敗
開發利用現狀:不詳
保護建議:不詳
遺傳多樣性:不詳
菌物界(五)
| “菌物界”這個名詞是我國學者裘維蕃等於1990年提出的,並已得學術界的一定支持,這是指與動物界,植物界相併列的一大群無葉綠素,依靠細胞表面吸收有機養料,細胞壁一般還有幾丁質的真核微生物。一般包括真菌,粘菌和假菌(卵菌等)3類。 |

